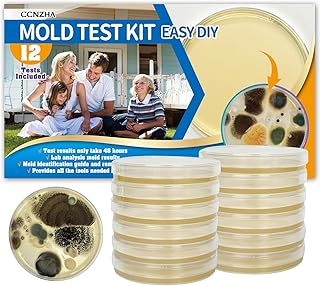
Mold Test Kit for Home -DIY Mold Testing Kit with 12 Individual Tests-Black Mold Detector-Indoor Air Quality Tester-Mold Identification Guide-Free Lab Analysis-Fast and Reliable Mold Detector at Home

Mold spores are a common concern in indoor environments, particularly in areas with high humidity or water damage. These microscopic particles can float in the air and settle on surfaces, potentially leading to mold growth if conditions are favorable. One of the most frequently asked questions about mold spores is how long they can survive in the environment. The answer to this question is complex and depends on various factors, including the type of mold, environmental conditions, and the presence of nutrients. In general, mold spores can remain viable for extended periods, ranging from a few days to several years, depending on the circumstances. Understanding the factors that influence mold spore survival is crucial for effective mold prevention and remediation strategies.
| Characteristics | Values |
|---|---|
| Mold Spores Lifespan | Mold spores can survive for a very long time, often years, depending on environmental conditions. |
| Environmental Conditions | Factors such as humidity, temperature, and light exposure can affect the viability of mold spores. |
| Humidity | High humidity levels can prolong the life of mold spores, while low humidity can cause them to become dormant. |
| Temperature | Mold spores can survive a wide range of temperatures, but extreme heat or cold can kill them. |
| Light Exposure | Some molds are sensitive to light, while others are not. UV light can be particularly effective at killing mold spores. |
| Surface Type | Mold spores can adhere to various surfaces, including wood, drywall, and fabric. The type of surface can influence their survival rate. |
| Mold Type | Different types of mold have varying levels of spore viability and resistance to environmental factors. |
Explore related products
What You'll Learn
- Factors Affecting Mold Spore Lifespan: Temperature, humidity, and environmental conditions impact how long mold spores can survive
- Common Types of Mold: Different species have varying lifespans; for example, Aspergillus and Penicillium are more persistent
- Mold Spores in the Air: Airborne spores can live for hours to days, depending on atmospheric conditions
- Mold Spores on Surfaces: Spores on porous materials like wood or fabric can survive longer than on non-porous surfaces
- Health Implications: Prolonged exposure to mold spores can cause respiratory issues and allergic reactions in susceptible individuals

Factors Affecting Mold Spore Lifespan: Temperature, humidity, and environmental conditions impact how long mold spores can survive
Mold spores are remarkably resilient and can survive in a variety of environmental conditions. However, their lifespan is significantly influenced by factors such as temperature, humidity, and the surrounding environment. Understanding these factors is crucial for effective mold prevention and remediation.
Temperature plays a critical role in mold spore survival. Mold spores can remain dormant for extended periods in cold temperatures, but they become more active and begin to germinate when temperatures rise. Optimal temperatures for mold growth typically range between 70°F and 90°F (21°C and 32°C). In contrast, temperatures above 100°F (38°C) or below 40°F (4°C) can inhibit mold growth and spore germination.
Humidity is another key factor affecting mold spore lifespan. Mold spores require moisture to germinate and grow, and they thrive in environments with high humidity levels. Relative humidity levels above 60% are conducive to mold growth, while levels below 50% can help prevent mold spores from germinating. Controlling humidity levels through proper ventilation, dehumidification, and moisture management is essential for reducing mold spore survival and growth.
Environmental conditions, such as the presence of organic matter and the type of surface mold spores land on, also impact their lifespan. Mold spores can survive on a variety of surfaces, including wood, drywall, carpet, and even metal. However, they are more likely to germinate and grow on surfaces that provide a suitable nutrient source, such as organic matter or moisture-retaining materials. Regular cleaning and maintenance of surfaces, as well as prompt removal of any organic matter or moisture, can help reduce the likelihood of mold spore germination and growth.
In conclusion, factors such as temperature, humidity, and environmental conditions play a significant role in determining the lifespan of mold spores. By understanding and controlling these factors, it is possible to reduce the likelihood of mold growth and spore germination, thereby improving indoor air quality and preventing potential health hazards associated with mold exposure.
Extending Mushroom Spore Lifespan: Fridge Storage Tips and Duration
You may want to see also
Explore related products

Common Types of Mold: Different species have varying lifespans; for example, Aspergillus and Penicillium are more persistent
Mold spores are a common concern in many households and buildings, and understanding their lifespan is crucial for effective mold prevention and remediation. Among the various types of mold, some species are more persistent than others, making them particularly challenging to eradicate. Aspergillus and Penicillium are two such examples that are known for their resilience and ability to thrive in a wide range of environments.
Aspergillus is a genus of molds that includes over 300 species, many of which are common in indoor environments. These molds can grow on a variety of surfaces, including wood, paper, and textiles, and are often found in areas with high humidity and poor ventilation. Aspergillus spores can remain viable for several months to a few years, depending on the species and environmental conditions. This persistence makes Aspergillus a significant concern for individuals with allergies or respiratory issues, as prolonged exposure can exacerbate these conditions.
Penicillium is another genus of molds that is commonly found in indoor environments. Like Aspergillus, Penicillium can grow on a wide range of surfaces and is particularly fond of damp, poorly ventilated areas. Penicillium spores can remain viable for several months to a few years, and some species are known to produce mycotoxins that can be harmful to humans and animals. Effective mold remediation strategies are essential for preventing the growth and spread of Penicillium and other persistent mold species.
In addition to Aspergillus and Penicillium, other common types of mold include Alternaria, Cladosporium, and Stachybotrys. Each of these species has its own unique characteristics and lifespans, but all can contribute to indoor air quality issues and health problems if left unchecked. Understanding the specific types of mold present in a building and their respective lifespans is crucial for developing an effective mold prevention and remediation plan.
To prevent the growth and spread of mold, it is essential to maintain a clean, dry, and well-ventilated environment. Regular cleaning and disinfection of surfaces, prompt repair of water leaks, and the use of dehumidifiers in high-humidity areas can all help to reduce the risk of mold growth. In cases where mold is already present, professional mold remediation services may be necessary to safely and effectively remove the mold and prevent its return.
In conclusion, the lifespan of mold spores can vary significantly depending on the species and environmental conditions. Persistent mold species like Aspergillus and Penicillium can remain viable for several months to a few years, making them a significant concern for indoor air quality and health. By understanding the specific types of mold present in a building and implementing effective prevention and remediation strategies, it is possible to reduce the risk of mold growth and create a healthier indoor environment.
Ozone's Power: Effectively Eliminating Mold Spores in Your Environment
You may want to see also
Explore related products

Mold Spores in the Air: Airborne spores can live for hours to days, depending on atmospheric conditions
Mold spores are microscopic particles that can become airborne and travel through the air. These spores can survive for varying lengths of time, depending on the environmental conditions they encounter. In ideal conditions, mold spores can remain viable for several days, allowing them to spread and potentially cause health issues for individuals who inhale them.
The survival of mold spores in the air is influenced by several factors, including humidity, temperature, and air currents. High humidity levels can help mold spores stay afloat and maintain their viability, while low humidity can cause them to dry out and die. Similarly, warm temperatures can promote the growth and spread of mold spores, while colder temperatures can slow down their activity. Air currents can also play a role in the dispersal of mold spores, as they can carry the spores from one location to another.
In addition to these environmental factors, the type of mold spore can also affect its survival time in the air. Some mold species, such as Aspergillus and Penicillium, are more resistant to environmental stressors and can survive for longer periods of time. Other mold species, such as Cladosporium and Alternaria, are more susceptible to environmental changes and may not survive as long.
Understanding the factors that influence the survival of mold spores in the air is important for preventing the spread of mold and protecting public health. By controlling humidity levels, maintaining proper ventilation, and regularly cleaning and disinfecting surfaces, individuals can reduce the risk of mold growth and minimize the potential health impacts of airborne mold spores.
Mastering Spore Print Storage: Tips for Long-Term Preservation and Use
You may want to see also
Explore related products

Mold Spores on Surfaces: Spores on porous materials like wood or fabric can survive longer than on non-porous surfaces
Mold spores are microscopic reproductive units produced by mold fungi. These spores are incredibly resilient and can survive in various environmental conditions, making them a common concern in both indoor and outdoor settings. When it comes to surfaces, the longevity of mold spores can vary significantly depending on the material's porosity.
On porous materials like wood or fabric, mold spores can find a more hospitable environment. These materials provide a larger surface area and can trap moisture, creating an ideal habitat for mold growth. As a result, mold spores on porous surfaces can survive for extended periods, potentially leading to persistent mold infestations if not addressed promptly.
In contrast, non-porous surfaces such as metal, glass, or plastic are less conducive to mold growth. These surfaces do not absorb moisture as readily, making it more challenging for mold spores to establish themselves. Consequently, mold spores on non-porous surfaces typically have a shorter lifespan and are less likely to cause long-term issues.
Understanding the difference in mold spore survival on various surfaces is crucial for effective mold prevention and remediation. For porous materials, regular cleaning and moisture control are essential to prevent mold growth. Non-porous surfaces, while less susceptible, should still be cleaned regularly to remove any potential mold spores before they can find a more suitable environment to thrive.
In summary, the survival of mold spores on surfaces is significantly influenced by the material's porosity. Porous materials like wood and fabric provide a more favorable environment for mold growth, allowing spores to survive longer and potentially cause persistent infestations. Non-porous surfaces, on the other hand, are less conducive to mold growth, resulting in a shorter lifespan for mold spores. This knowledge is vital for implementing effective mold prevention and remediation strategies in various settings.
Identifying Black Mold Spores on Leather: Appearance and Characteristics
You may want to see also
Explore related products

Health Implications: Prolonged exposure to mold spores can cause respiratory issues and allergic reactions in susceptible individuals
Prolonged exposure to mold spores can have significant health implications, particularly for susceptible individuals. Respiratory issues are among the most common problems associated with mold exposure. Inhaling mold spores can irritate the airways, leading to symptoms such as coughing, wheezing, and shortness of breath. For people with asthma or other respiratory conditions, mold exposure can trigger severe asthma attacks or exacerbate existing symptoms.
Allergic reactions are another major concern. Mold spores can cause allergic rhinitis, which manifests as sneezing, runny nose, and itchy eyes. Skin rashes and hives may also occur in some individuals. In more severe cases, prolonged mold exposure can lead to chronic sinus infections or even fungal infections in the lungs.
Susceptible individuals include those with weakened immune systems, such as people undergoing chemotherapy or those with HIV/AIDS. Pregnant women, infants, and the elderly are also at higher risk. It is crucial for these individuals to avoid prolonged exposure to mold and to take steps to reduce mold growth in their living environments.
To mitigate the health risks associated with mold exposure, it is important to identify and address mold growth promptly. Regular cleaning and maintenance of living spaces can help prevent mold buildup. Using air purifiers and dehumidifiers can also be effective in reducing mold spore levels in the air. In cases of severe mold infestation, professional mold remediation services may be necessary to ensure thorough removal and prevent future growth.
In conclusion, understanding the health implications of prolonged mold exposure is essential for taking appropriate preventive measures. By being aware of the risks and taking proactive steps to reduce mold growth, individuals can protect their health and create a safer living environment.
How Long Do Spore Prints Last: A Comprehensive Guide
You may want to see also
Frequently asked questions
Mold spores can survive in the air for a considerable period, ranging from a few hours to several days, depending on environmental conditions such as humidity, temperature, and air currents.
While mold spores can remain viable on surfaces for extended periods, they typically do not live indefinitely. The survival time can vary from a few days to several months, depending on the type of surface and environmental conditions.
Mold spores can be inactivated or killed when exposed to direct sunlight for a prolonged period. UV radiation from sunlight can disrupt the spores' DNA, rendering them unable to germinate and grow.
Mold spores can survive in water for a shorter duration compared to air or surfaces. They typically remain viable for a few days to a few weeks in water, depending on factors such as temperature and the presence of other microorganisms.